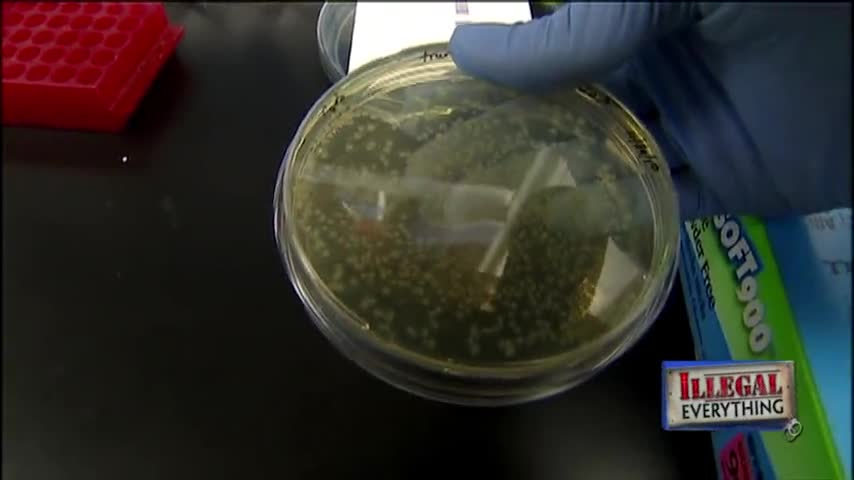
Classic Stossel: Illegal Food

Premium Only Content
This video is only available to Rumble Premium subscribers. Subscribe to
enjoy exclusive content and ad-free viewing.
Classic Stossel: Illegal Food
Loading comments...
-
 0:48
0:48
ThingsThatMatter
1 hour agoDigital IDs Quietly Added to AppStore and Very Few Are Talking About It
3 -
 5:31
5:31
John Rich Official
12 days agoThe Righteous Hunter by John Rich
1.05K2 -
 48:48
48:48
The Culture War with Tim Pool
1 hour agoThe West Is COLLAPSING Under Mass Migration | The Culture War's Across The Pond
1.8K21 -
 LIVE
LIVE
The Mel K Show
1 hour agoMORNINGS WITH MEL K - We Have Not Yet Begun to Fight - The Clock is Ticking! 11-28-25
603 watching -
 LIVE
LIVE
Film Threat
13 hours agoHOLLYWOOD FOR SALE! BLACK FRIDAY BLOW OUT! | Film Threat Livecast
98 watching -
 LIVE
LIVE
The Shannon Joy Show
1 hour agoSJ Show Nov 28 - The SJ Friday Matinee Watch Party With Commentary Featuring The Big Short!
202 watching -
 LIVE
LIVE
Grant Stinchfield
3 hours agoThe Medical Deep State Exposed — And McCullough Has the Receipts!
146 watching -
 LIVE
LIVE
Trumpet Daily
49 minutes agoTrumpet Daily LIVE | Nov. 28, 2025
387 watching -
 LIVE
LIVE
LFA TV
14 hours agoLIVE & BREAKING NEWS! | FRIDAY 11/28/25
7,216 watching -
 2:00:18
2:00:18
Badlands Media
11 hours agoBadlands Daily – Nov. 28, 2025
76.1K13